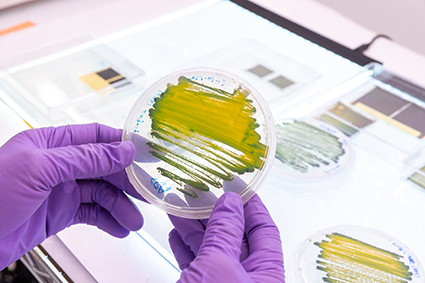

Biomining
Harnessing biology to transform copper extraction
challenge
What’s the problem we’re trying to
solve?
As the demand for copper continues to surge, we face a stark reality: conventional mining methods are unsustainable for the long haul. Traditional extraction relies on high temperatures, chemicals, and heavy infrastructure — often producing large amounts of waste and environmental harm, especially when targeting low-grade ores.
But what if we could mine copper the way nature does? Quietly, precisely and with far less waste.


solution
How does this research provide a solution?
Biomining turns to some of the smallest organisms on the planet — microbes — to solve one of the biggest challenges in modern mining. By leveraging the unique abilities of bacteria, archaea, fungi, and the viruses that infect them this research is exploring how to extract copper from ores and waste materials in ways that are cleaner, more efficient, and more adaptable to varied environments.
Microorganisms naturally break down minerals, releasing metals like copper into soluble forms — a process known as biohydrometallurgy. This method not only reduces environmental impact but also enables extraction from low-grade ores and mine waste that would otherwise go unused.
But copper biomining isn’t without its complexities. Each microbe behaves differently depending on ore type, temperature, pH, and other factors. To make biomining a scalable, effective alternative, the process must be precisely tuned — and that’s where biotechnology innovation comes in.
process

What exactly are we doing?
This research work package is building a next-generation biotechnology toolkit for sustainable copper recovery. The team is working on:
- Biological discovery: Creating a resource engine to identify genes, proteins, and biological components with a high affinity for binding copper.
- Surface display (SD) platforms: Engineering modular systems — such as modified cells, membranes, bacteriophages, and lipid nanoparticles — that can attach to and capture copper from complex materials.
- Smart process development: Using high-throughput automation and advanced experimental design to simulate real-world mining conditions and refine performance.
- Hybrid living materials (HLMs): Developing new bio-based materials that integrate these engineered components into scalable, sustainable copper recovery systems.
Together, these innovations represent a step change in how we think about mineral processing — combining biotechnology, materials science, and systems engineering into a new paradigm for resource extraction.
team
Who’s involved?
This work package is led by two pioneers in microbial biotechnology:
- Seung-Wuk Lee – University of California, Berkeley
- Steven Hallam – University of British Columbia
Their teams are combining deep expertise in microbial ecology, environmental genomics, synthetic biology, biomaterial design and environmental engineering to create bio-enabled solutions that can function across a variety of mining environments and ore types.


goals
What are our objectives and long-term goals?
- Identify and characterise new biological components with copper-binding capabilities
- Build and optimise modular biotechnology platforms for selective copper recovery
- Create scalable processes that work across a wide range of ore bodies and site conditions
- Reduce energy consumption, water usage, and waste generation in copper mining
- Establish a foundation for bio-based extraction methods that can be extended to other metals and materials
Ultimately, this research aims to build a new class of biomining tools that don’t just work in the lab — but in the real world, where cleaner, smarter, and more sustainable mining solutions are urgently needed.

read more
Further reading
- Davenport B, Hallam SJ. Emerging enzyme surface display systems for waste resource recovery. Environ Microbiol. 2023 Feb;25(2):241-249. doi: 10.1111/1462-2920.16284. Epub 2022 Nov 21. PMID: 36369958; PMCID: PMC10100002
- Morgan-Lang C, Hallam SJ.Curr Protoc. 2023 Feb;3(2):e671. doi: 10.1002/cpz1.671.PMID: 36801973
Sign up
to our newsletter
Stay informed with the latest research breakthroughs, expert insights and updates from the Rio Tinto Centre for Future Materials. Sign up to our newsletter to connect with a global community driving innovation in sustainable materials and the energy transition.